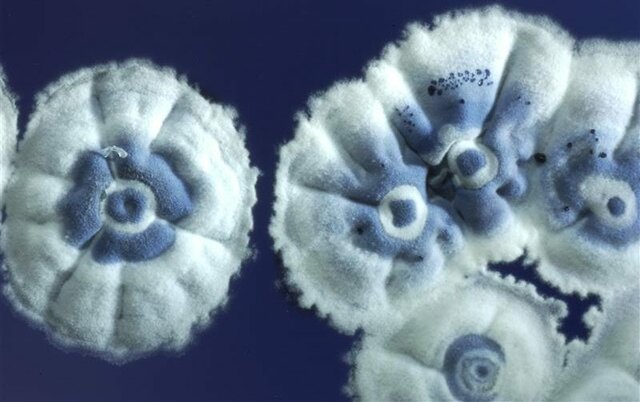
Hopwood y col.

-
 Propone que las enfermedades son causadas por organismos invisibles.
Propone que las enfermedades son causadas por organismos invisibles. -
Desarrolla el primer microscopio útil compuesto
-
 Fue el primero en refutar la teoría de la generación espontánea en gusanos.
Fue el primero en refutar la teoría de la generación espontánea en gusanos. -
 Es el primero en observar bacterias o "animálculos".
Es el primero en observar bacterias o "animálculos". -
 Publica su trabajo sobre la generación espontánea de los gusanos.
Publica su trabajo sobre la generación espontánea de los gusanos. -
 Describe la primera clasificación de bacterias.
Describe la primera clasificación de bacterias. -
 Desarrolla la primera vacuna contra la viruela humana.
Desarrolla la primera vacuna contra la viruela humana. -
Demuestra que una enfermedad del gusano de seda está causada por un hongo y propone que muchas enfermedades son de origen microbiano
-
Desarrollan la teoría celular.
-
Demuestra que la fiebre puerperal está causada por los médicos e introduce el uso del antiséptico para así evitarla.
-
 Demuestra que la fermentación del ácido láctico se debe a un microorganismo.
Demuestra que la fermentación del ácido láctico se debe a un microorganismo. -
 Afirma que todas las células proceden de células.
Afirma que todas las células proceden de células. -
 Refuta de manera convincente la teoría de la generación espontánea.
Refuta de manera convincente la teoría de la generación espontánea. -
 Demuestra que los organismo no se originan por generación espontánea.
Demuestra que los organismo no se originan por generación espontánea. -
 Publica su trabajo sobre cirugía antiséptica.
Publica su trabajo sobre cirugía antiséptica. -
 Descubre el DNA (ácido nucleico) en el esperma de trucha
Descubre el DNA (ácido nucleico) en el esperma de trucha -
Demuestra que el carbunco es causado por Bacillus anthracis.
-
 Descubre la fagocitosis.
Descubre la fagocitosis. -
 Se desarrolla la tinción de Gram.
Se desarrolla la tinción de Gram. -
 Desarrolla el autoclave.
Desarrolla el autoclave. -
 Prepara la vacuna contra la rabia.
Prepara la vacuna contra la rabia. -
 Diseña la placa petri.
Diseña la placa petri. -
 Presenta métodos bioquímicos para el estudio de bacterias.
Presenta métodos bioquímicos para el estudio de bacterias. -
 Prepara antitoxinas para la difteria y el tétanos.
Prepara antitoxinas para la difteria y el tétanos. -
 Demuestra que el parásito del paludismo es transportado por un mosquito
Demuestra que el parásito del paludismo es transportado por un mosquito -
 Demuestra que una partícula viral causa la enfermedad del mosaico del tabaco.
Demuestra que una partícula viral causa la enfermedad del mosaico del tabaco. -
 Descubre los grupos sanguíneos.
Descubre los grupos sanguíneos. -
Muestran que la espiroqueta Treponema pallidum es el agente productor de la sífilis.
-
 Desarrolla la prueba de fijación del complemento para detectar la sífilis.
Desarrolla la prueba de fijación del complemento para detectar la sífilis. -
 Desarrolla un agente quimioterapéutico frente a la sífilis.
Desarrolla un agente quimioterapéutico frente a la sífilis. -
Descubren virus bacterianos.
-
 Descubre la lisozima.
Descubre la lisozima. -
 Descubre la transformación bacteriana
Descubre la transformación bacteriana -
 Descubre la penicilina.
Descubre la penicilina. -
 Desarrolla el primer microscopio electrónico de transmisión.
Desarrolla el primer microscopio electrónico de transmisión. -
 Descubre las sulfamidas.
Descubre las sulfamidas. -
 Clasifica los organismos vivos en procariotas y eucariotas.
Clasifica los organismos vivos en procariotas y eucariotas. -
 Proponen que la estructura del ADN es de doble hélice.
Proponen que la estructura del ADN es de doble hélice. -
 Desarrolla la técnica de radioinmunoensayo
Desarrolla la técnica de radioinmunoensayo -
 Descubren las endonucleasas de restricción.
Descubren las endonucleasas de restricción. -
Descubrimiento del ARN catalítico.
-
Aíslan e identifican el virus de la inmunodeficiencia humana.
-
 Se aprueba el uso en los seres humanos de la primera vacuna producida por ingeniera genética contra la hepatitis B.
Se aprueba el uso en los seres humanos de la primera vacuna producida por ingeniera genética contra la hepatitis B. -
 Demuestra que la fiebre amarilla es transmitida por los mosquitos.
Demuestra que la fiebre amarilla es transmitida por los mosquitos. -
 Comienzan los primeros análisis en genoterapia humana.
Comienzan los primeros análisis en genoterapia humana. -
 Descubren Epulopiscium fishelsoni, la mayor célula procariota.
Descubren Epulopiscium fishelsoni, la mayor célula procariota. -
 Demuestra que el ADN transporta información durante la transformación.
Demuestra que el ADN transporta información durante la transformación. -
 Descubre la estreptomicina.
Descubre la estreptomicina. -
 Se aprueba la vacuna de varicela en EE UU
Se aprueba la vacuna de varicela en EE UU -
 Se descubre la bacteria gigante Thiomargarita namibiensis.
Se descubre la bacteria gigante Thiomargarita namibiensis. -
Realizaron la secuenciación del genoma de Streptomyces coelicolor.
Realizaron la secuenciación del genoma de Streptomyces coelicolor. -
 H5N1 es una cepa altamente patógena de gripe aviar. La primera aparición de este tipo de gripe en humanos se dio en 1997 en Hong Kong.1 La infección en humanos coincidió con una epidemia de gripe aviaria, causada por la misma cepa, en la población de pollos en Hong Kong. El nombre H5N1 se refiere al tipo de los antígenos de superficie presentes en el virus: hemaglutinina tipo 5 y neuraminidasa tipo 1.
H5N1 es una cepa altamente patógena de gripe aviar. La primera aparición de este tipo de gripe en humanos se dio en 1997 en Hong Kong.1 La infección en humanos coincidió con una epidemia de gripe aviaria, causada por la misma cepa, en la población de pollos en Hong Kong. El nombre H5N1 se refiere al tipo de los antígenos de superficie presentes en el virus: hemaglutinina tipo 5 y neuraminidasa tipo 1. -
 Los australianos Barry J. Marshall y J. Robin Warren lo obtuvieron por sus trabajos sobre la bacteria Helicobacter pylori y su papel en el desarrollo de la gastritis y la úlcera péptica.
Los australianos Barry J. Marshall y J. Robin Warren lo obtuvieron por sus trabajos sobre la bacteria Helicobacter pylori y su papel en el desarrollo de la gastritis y la úlcera péptica. -
 Se secuencia el genoma del Saccharopolyspora erythraea, el microorganismo productor del antibiótico eritromicina.
Se secuencia el genoma del Saccharopolyspora erythraea, el microorganismo productor del antibiótico eritromicina. -
 En México aparece un brote de gripe porcina, posteriormente llamada gripe A H1N1.
En México aparece un brote de gripe porcina, posteriormente llamada gripe A H1N1. -
 caracterización "in vivo" e "in vitro" del virus H1N1.
caracterización "in vivo" e "in vitro" del virus H1N1. -
 Se descubre el procesode esporulación en Mycobacterium.
Se descubre el procesode esporulación en Mycobacterium. -
 B. subtilis se ha mostrado muy manejable para la manipulación genética, y se ha hecho, por lo tanto, extensamente adoptado como un organismo modelo para estudios de laboratorio, sobre todo de esporulación, que es un ejemplo simplificado de la diferenciación celular. En términos de popularidad como un organismo modelo de laboratorio B. subtilis a menudo es usado como el equivalente Gram positivo de Escherichia coli, un bacilo Gram negativo estudiado extensivamente.
B. subtilis se ha mostrado muy manejable para la manipulación genética, y se ha hecho, por lo tanto, extensamente adoptado como un organismo modelo para estudios de laboratorio, sobre todo de esporulación, que es un ejemplo simplificado de la diferenciación celular. En términos de popularidad como un organismo modelo de laboratorio B. subtilis a menudo es usado como el equivalente Gram positivo de Escherichia coli, un bacilo Gram negativo estudiado extensivamente. -
 El influenzavirus A subtipo H1N1, mejor conocido como gripe A H1N1 humana o indistintamente A N1H1 humana, es un subtipo de influenzavirus tipo A del virus de la gripe, perteneciente a la familia de los Orthomyxoviridae.
El influenzavirus A subtipo H1N1, mejor conocido como gripe A H1N1 humana o indistintamente A N1H1 humana, es un subtipo de influenzavirus tipo A del virus de la gripe, perteneciente a la familia de los Orthomyxoviridae.
El H1N1 ha mutado en diversos subtipos que incluyen la gripe española (extinta en la vida silvestre), la gripe porcina, la gripe aviar y la gripe bovina. La cepa mantiene su circulación después de haber sido reintroducida por la población humana en los años 1970. -
 Creación del primer microorganismo sintético (Mycoplasma mycoides), a la que se le había reemplazado su genoma natural por uno diseñado, sintetizado y ensamblado completamente. La nueva bacteria denominada Mycoplasma mycoides JCVI-syn1.0 estaba, por tanto, controlada por el cromosoma sintético y era capaz de multiplicarse y autoreplicarse de forma autónoma.
Creación del primer microorganismo sintético (Mycoplasma mycoides), a la que se le había reemplazado su genoma natural por uno diseñado, sintetizado y ensamblado completamente. La nueva bacteria denominada Mycoplasma mycoides JCVI-syn1.0 estaba, por tanto, controlada por el cromosoma sintético y era capaz de multiplicarse y autoreplicarse de forma autónoma. -
 Desarrollan un “ichip” (isolation chip, cápsula de aislamiento),de plástico, que permite masificar el proceso para el cultivo de bacterias.
Desarrollan un “ichip” (isolation chip, cápsula de aislamiento),de plástico, que permite masificar el proceso para el cultivo de bacterias. -
 Se desarrolla un nuevo antibiótico a partir de la bacteria Eleftheria terrae; la teixobactina, un antibiótico que ataca a un tipo de bacterias denominado Gram positivo.
Se desarrolla un nuevo antibiótico a partir de la bacteria Eleftheria terrae; la teixobactina, un antibiótico que ataca a un tipo de bacterias denominado Gram positivo. -
 Se utiliza esta bacteria para controlar la crisis por dengue.
Se utiliza esta bacteria para controlar la crisis por dengue. -
 La OMS anuncia las 12 familias de bacterias resistentes a los antibióticos que representan las mayores amenazas de salud.
La OMS anuncia las 12 familias de bacterias resistentes a los antibióticos que representan las mayores amenazas de salud. -
 La vacuna Ervebo Ébola Zaire fue autorizada en 2019 por la Agencia Europea de Medicamentos y la Administración de Alimentos y Medicamentos de los Estados Unidos (FDA), antes de ser precalificada por la OMS y aprobada por ocho países africanos.
La vacuna Ervebo Ébola Zaire fue autorizada en 2019 por la Agencia Europea de Medicamentos y la Administración de Alimentos y Medicamentos de los Estados Unidos (FDA), antes de ser precalificada por la OMS y aprobada por ocho países africanos. -
 Primeros casos de neumonía reportados por la OMS, por un virus desconocido.
Primeros casos de neumonía reportados por la OMS, por un virus desconocido. -
 La OMS nombra el nuevo coronavirus como COVID-19.
La OMS nombra el nuevo coronavirus como COVID-19.
La OMS declara que el nuevo brote por coronavirus es una pandemia. -
 La Administración de Alimentos y Medicamentos de los EE. UU. (FDA, por sus siglas en inglés) aprobó la primera vacuna contra el COVID-19.
La Administración de Alimentos y Medicamentos de los EE. UU. (FDA, por sus siglas en inglés) aprobó la primera vacuna contra el COVID-19.
Want to make a timeline like this?
Use Timetoast to turn dates, events, milestones, and phases into a clear visual timeline you can build and share. Timetoast is a timeline maker for work, school, research, and stories.
